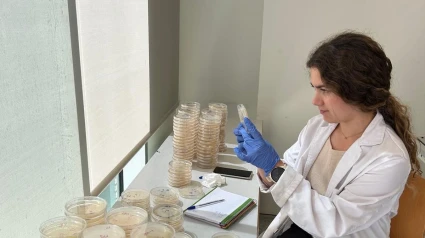
.

La paja del arroz que se tiraba ahora puede alargar la vida del pescado
Un equipo investigador de la UPV desarrolla plásticos biodegradables con restos de arroz, uva y chufa
Valencia - Publicado el
2 min lectura7:21 min escucha
Cada año, cuando el cultivo del arroz llega a su fin en la Comunitat Valenciana, vuelve el mismo debate: ¿qué hacer con la paja del arroz? Para los agricultores, la respuesta está clara: “hay que quemarla, como se ha hecho durante siglos”. Sin embargo, las restricciones medioambientales y las emisiones contaminantes obligan a buscar nuevas alternativas para aprovechar este residuo. Este año, una investigación de la Universitat Politècnica de València (UPV) abre una vía muy prometedora: convertir la paja del arroz —junto con otros residuos como la chufa o la uva— en envases biodegradables para alimentos.
El proyecto, liderado por el Instituto Universitario de Ingeniería de Alimentos de la UPV, pretende dar valor a estos subproductos del campo valenciano. “Utilizamos residuos agroalimentarios como material de relleno para plásticos biodegradables. Así, además de abaratar costes, conseguimos dotarlos de propiedades que alargan la vida útil de los alimentos”, explica Chelo González, secretaria de la UPV e investigadora principal del estudio.
El secreto está en los compuestos fenólicos, presentes en estos residuos, que tienen efectos antioxidantes y antimicrobianos. De este modo, los envases no solo son más sostenibles, sino que también contribuyen a mantener la calidad del pescado, la carne o la fruta durante más tiempo.
Aunque no se trata de plásticos en el sentido tradicional —ya que no proceden del petróleo—, estos nuevos materiales imitan su apariencia y funcionalidad. “El plástico como tal no lo formamos con la paja, sino que usamos materiales biodegradables y los mezclamos con estos residuos. Así reducimos la cantidad de polímero y abaratamos el producto final”, detalla González.
De momento, el equipo ha trabajado con plásticos flexibles para aplicaciones como bolsas monodosis o envoltorios alimentarios. “Estamos estudiando cómo fabricar bandejas más rígidas, pero necesitamos más equipamiento para avanzar en ese campo”, añade.
El reto, como en tantas otras innovaciones sostenibles, está en el coste. “El problema principal es el precio. Si estos envases fueran más baratos, seguro que se usarían más. Pero para eso se necesita una implicación de toda la sociedad: industria, consumidores y administración”, subraya la investigadora. Porque aunque la tecnología ya lo permite, su implantación real depende del mercado y de políticas públicas decididas a fomentar una economía circular.
Desde la UPV reclaman más apoyo a proyectos de este tipo y recuerdan que la sostenibilidad no es una opción, sino una necesidad. “Podemos transformar un residuo en un recurso útil para todos. Poder, se puede. Pero necesitamos que se quiera”, concluye González.
Esta investigación se suma a otras iniciativas que buscan alternativas al uso de plásticos convencionales y marcan un camino claro: el del aprovechamiento de los residuos agrícolas como fuente de innovación sostenible. Mientras tanto, toneladas de paja del arroz siguen esperando una segunda vida… quizás en forma de bandeja para el pescado que compras en el supermercado.



